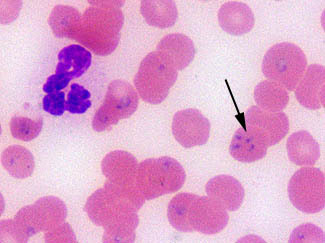

UNDERSTANDING EQUINE BLOODWORK UBW@groups.io
This is the group for Dr Kellon's understanding equine bloodwork course. Membership is by registration only, www.drkellon.com.
Informações do grupo
- http://drkellon.com/coursedescriptions/understandingbloodwork.html
- Membros do 103
- 172 Tópicos , Última postagem:
- Iniciado em
Endereços de e-mail do grupo
- Postar: UBW@groups.io
- Assine: UBW+subscribe@groups.io
- Cancelar inscrição: UBW+unsubscribe@groups.io
- Proprietário do grupo: UBW+owner@groups.io
- Ajuda: UBW+help@groups.io
Configurações de grupo
- Todos os membros podem postar no grupo.
- Publicações neste grupo não precisam da aprovação dos moderadores.
- As publicações de novos usuários precisam da aprovação dos moderadores.
- As mensagens são definidas para responder ao grupo.
- As inscrições nesse grupo não precisam da aprovação dos moderadores.
- O arquivo é visível apenas para membros.
- O Wiki é visível apenas para membros.
- Os membros podem editar suas mensagens.
- Os membros podem definir suas assinaturas como sem e-mail.
